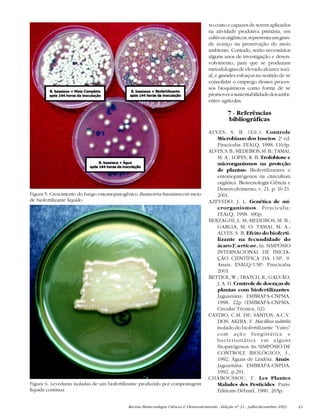
Revista Biotecnologia Ciência & Desenvolvimento - Edição nº 31 - julho/dezembro 2003 43
Figura 5. Crescimento do fungo entomopatogênico Beauveria bassiana em meio
de biofertilizante líquido
Figura 6. Leveduras isoladas de um biofertilizante produzido por compostagem
líquida contínua
xo custo e capazes de serem aplicados
na atividade produtiva primária, em
cultivosorgânicos,representaumgran-
de avanço na preservação do meio
ambiente. Contudo, serão necessários
alguns anos de investigação e desen-
volvimento, para que se produzam
metodologias de elevado alcance soci-
al, e grandes esforços no sentido de se
consolidar o emprego desses proces-
sos bioquímicos como forma de se
promoverasustentabilidadedosambi-
entes agrícolas.
7 - Referências
bibliográficas
ALVES, S. B. (Ed.). Controle
Microbiano dos Insetos. 2a
ed.
Piracicaba: FEALQ, 1998. 1163p.
ALVES,S.B.;MEDEIROS,M.B.;TAMAI,
M. A.; LOPES, R. B. Trofobiose e
microrganismos na proteção
de plantas: Biofertilizantes e
entomopatógenos na citricultura
orgânica. Biotecnologia Ciência e
Desenvolvimento, v. 21. p. 16-21.
2001.
AZEVEDO, J. L. Genética de mi-
crorganismos. Piracicaba:
FEALQ, 1998. 490p.
BERZAGHI, L. M; MEDEIROS, M. B.;
GARCIA, M. O. TAMAI, M. A.;
ALVES, S. B. Efeito do bioferti-
lizante na fecundidade do
ácaro T. urticae. In: SIMPÓSIO
INTERNACIONAL DE INICIA-
ÇÃO CIENTÍFICA DA USP, 9.
Anais. ESALQ/USP: Piracicaba
2001
BETTIOL, W.; TRATCH, R.; GALVÃO,
J. A. H. Controle de doenças de
plantas com biofertilizantes.
Jaguariúna: EMBRAPA-CNPMA.
1998. 22p (EMBRAPA-CNPMA:
Circular Técnica, 02).
CASTRO, C.M. DE; SANTOS, A.C.V.
DOS; AKIBA, F. Bacillus subtilis
isolado do biofertilizante “Vairo”
com ação fungistática e
bacteriostática em alguns
fitopatógenos. In: SIMPÓSIO DE
CONTROLE BIOLÓGICO, 3.,
1992, Águas de Lindóia. Anais.
Jaguariúna: EMBRAPA-CNPDA.
1992. p.291.
CHABOUSSOU, F. Les Plantes
Malades des Pesticides. Paris:
Editions Débard, 1980. 265p.

O documento discute o uso de biofertilizantes líquidos na agricultura orgânica para o controle de pragas e doenças de plantas. Os biofertilizantes contêm microrganismos e metabólitos que ajudam a equilibrar a nutrição da planta e induzir sua resistência, reduzindo o ataque de pragas e doenças. Estudos mostraram que os biofertilizantes podem ter efeitos fungistáticos, bacteriostáticos, repelentes e inibidores de alimentação contra vários pragas